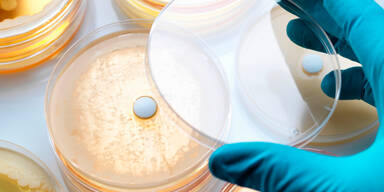
Antibiotika

EU-Behörde fordert Reduzierung des Reserveantibiotikums Colistin
Die Europäische Arzneimittel-Agentur EMA fordert, die Verwendung des Antibiotikums Colistin bei Tieren drastisch einzuschränken. Der Verkauf von colistinhaltigen Medikamenten in der EU solle um 65 Prozent verringert werden, um die Entwicklung von resistenten Erregern einzuschränken, empfiehlt die Agentur.
Neubewertung von Colistin
Die EU-Kommission hatte um eine Neubewertung von Colistin gebeten, nachdem bei Bakterien ein bisher unbekanntes Gen nachgewiesen wurde, das die Entwicklung einer Colistin-Resistenz erheblich beschleunigen kann. Colistin gilt in der Humanmedizin als Reserveantibiotikum und wird seit mehr als 50 Jahren verwendet. Reserveantibiotika sind in der Therapie von Menschen bedeutsam, wenn herkömmliche Antibiotika nicht mehr helfen und sind das letzte Mittel gegen resistente Keime . Bei Tieren wird Colistin inzwischen immer häufiger für die Behandlung von Infektionen mit Darmbakterien eingesetzt.